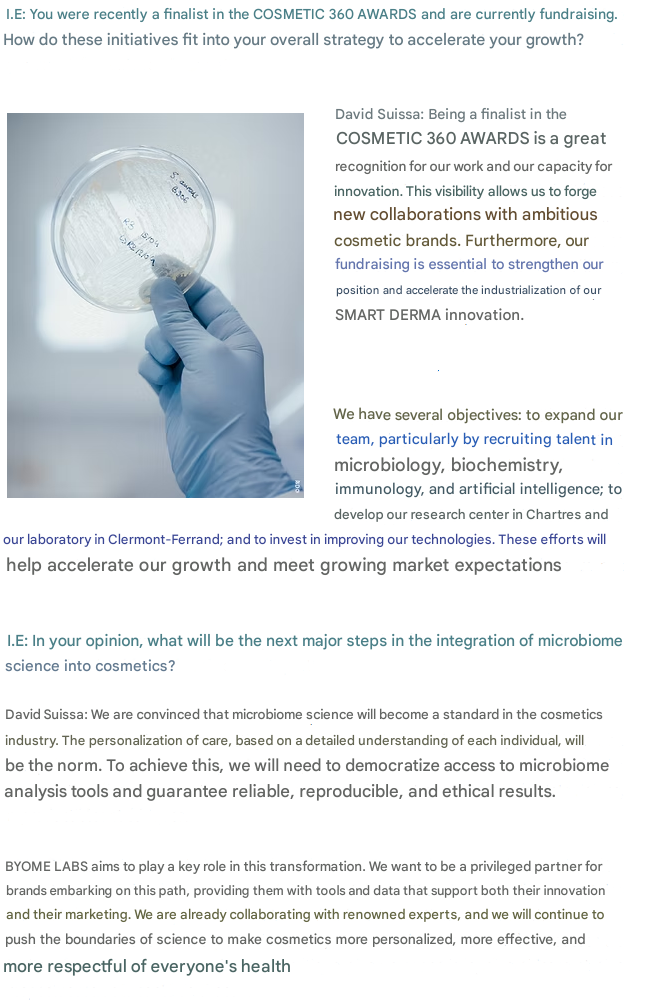

Notre site utilise des cookies pour améliorer votre expérience de navigation. En continuant à utiliser notre site, vous acceptez notre utilisation de cookies conformément à notre politique de confidentialité.
Le stockage technique ou l'accès est strictement nécessaire dans le but légitime de permettre l'utilisation d'un service spécifique explicitement demandé par l'abonné ou l'utilisateur, ou dans le seul but d'effectuer la transmission d'une communication sur un réseau de communications électroniques.
L’accès ou le stockage technique est nécessaire dans la finalité d’intérêt légitime de stocker des préférences qui ne sont pas demandées par l’abonné ou l’internaute.
Le stockage ou l'accès technique utilisé exclusivement à des fins statistiques. Le stockage ou l'accès technique utilisé exclusivement à des fins statistiques.
Le stockage ou l'accès technique est nécessaire pour créer des profils d'utilisateurs afin d'envoyer de la publicité, ou pour suivre l'utilisateur sur un site web ou sur plusieurs sites web à des fins de marketing similaires.